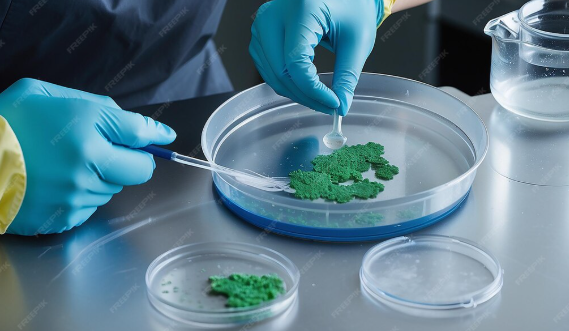
Surgeon using irrigation solution during implant surgery to prevent biofilm formation and reduce infection risk.

The Role of Surgical Irrigation in Preventing Biofilm Formation on Implants
- Updated on: Apr 7, 2026
- 3 min Read
Implant-based procedures—whether orthopedic, spinal, or soft-tissue—have transformed modern medicine. But one of the most persistent challenges tied to implants is biofilm formation, a hidden but serious contributor to surgical complications.
Today, advanced surgical irrigation solutions are playing a critical role in preventing biofilm development before it starts. Medical technology companies like Sanara MedTech are leading this shift by developing irrigation and cleansing formulations designed to reduce bacterial load and support better surgical outcomes.
Here’s how surgical irrigation helps prevent biofilm formation on implants—and why it matters.
What Is Biofilm and Why Is It a Problem?
Biofilm is a structured community of bacteria that attaches to surfaces—especially medical implants—and forms a protective barrier.
Once biofilm develops, it becomes:
- Extremely resistant to antibiotics
- Difficult for the immune system to eliminate
- A source of chronic infection
- A major cause of implant failure
In surgical settings, even a small amount of bacterial contamination can lead to biofilm formation if not properly addressed.
Why Implants Are Vulnerable to Biofilm
Implants provide an ideal surface for bacteria to attach and grow.
Factors that increase risk include:
- Surgical exposure to bacteria
- Presence of foreign material in the body
- Limited blood flow around implant surfaces
- Early-stage contamination during surgery
Once bacteria adhere to an implant, they can rapidly form biofilm—often before symptoms appear.
This makes early prevention during surgery critical.
The Role of Surgical Irrigation in Biofilm Prevention
Surgical irrigation is one of the most effective tools available for reducing contamination during procedures.
Modern irrigation solutions go beyond simple rinsing—they actively work to prevent biofilm formation.
1. Reducing Initial Bacterial Load
The first step in preventing biofilm is minimizing bacteria at the surgical site.
Advanced irrigation solutions:
- Flush out contaminants and debris
- Reduce microbial presence
- Clean implant surfaces before closure
By lowering bacterial load early, the risk of biofilm formation decreases significantly.
2. Disrupting Bacterial Attachment
Biofilm begins when bacteria attach to a surface.
Antimicrobial irrigation solutions help:
- Prevent bacteria from adhering to implants
- Disrupt early-stage bacterial colonization
- Interfere with the formation of protective biofilm layers
This is critical in the first moments after implant placement.
3. Breaking Down Biofilm Precursors
Before mature biofilm forms, bacteria begin producing extracellular substances that help them attach and grow.
Advanced irrigation formulations can:
- Disrupt these early biofilm components
- Break down organic material that supports bacterial growth
- Create a less favorable environment for colonization
This proactive approach targets biofilm at its earliest stage.
4. Supporting a Clean Surgical Environment
A clean surgical field is essential for successful outcomes.
Surgical irrigation helps:
- Remove tissue debris and contaminants
- Reduce inflammatory triggers
- Maintain a balanced environment for healing
This supports both infection prevention and tissue repair.
How Sanara MedTech Approaches Surgical Irrigation
Sanara MedTech develops advanced irrigation and cleansing solutions designed to integrate seamlessly into surgical workflows.
Their solutions focus on:
- Reducing bacterial load during procedures
- Disrupting biofilm formation
- Supporting tissue integrity around implants
- Enhancing overall surgical outcomes
These formulations are used alongside biologic and regenerative products to provide a comprehensive approach to surgical care.
Combining Irrigation with Biologic Technologies
Preventing biofilm is only part of the equation—supporting healing is equally important.
Sanara MedTech combines antimicrobial irrigation with biologic solutions such as:
- Activated collagen products
- Extracellular matrix materials
- Tissue repair grafts
This dual approach:
- Protects against infection
- Supports tissue regeneration
- Improves long-term implant success
The Impact on Surgical Outcomes
Preventing biofilm formation has a direct impact on patient outcomes.
When biofilm is avoided:
- Infection rates decrease
- Implant success rates improve
- Recovery times shorten
- Need for revision surgery is reduced
For healthcare providers, this means better results and fewer complications.
The Cost Implications of Biofilm Prevention
Biofilm-related infections are among the most expensive complications in healthcare.
They often lead to:
- Extended hospital stays
- Additional surgical procedures
- Long-term antibiotic use
- Increased resource utilization
By preventing biofilm formation during surgery, advanced irrigation solutions help reduce these costs significantly.
Applications Across Surgical Specialties
Surgical irrigation plays a role in many types of implant procedures, including:
- Orthopedic surgeries (joint replacements, fracture repair)
- Spinal procedures
- Soft tissue and reconstructive surgeries
- Wound debridement and implant revision
Sanara MedTech’s solutions are designed to support these applications across both acute and post-operative care settings.
Why Early Intervention Matters Most
Once biofilm is fully established, it becomes extremely difficult to treat.
That’s why prevention during surgery is the most effective strategy.
Surgical irrigation:
- Targets bacteria before they attach
- Reduces the risk of long-term complications
- Improves the likelihood of successful healing
Early action leads to better outcomes.
The Future of Biofilm Prevention in Surgery
As medical technology continues to advance, infection prevention is becoming more proactive and biologically driven.
Future trends include:
- More advanced antimicrobial formulations
- Integration with regenerative medicine
- Improved surgical protocols focused on prevention
Sanara MedTech is positioned at the forefront of this evolution, developing solutions that address both infection control and tissue healing.
Final Thoughts
Biofilm formation on implants is a serious challenge—but it is increasingly preventable.
Surgical irrigation plays a critical role by reducing bacterial load, disrupting early biofilm development, and supporting a clean surgical environment.
Sanara MedTech continues to lead in this space, providing advanced solutions that help surgeons improve outcomes, protect implants, and reduce complications.












